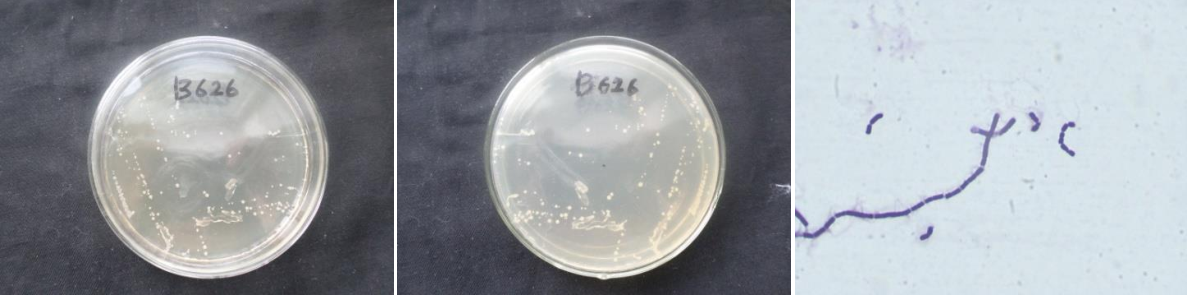

Loading...
| StrainNO | B626 |
| Classification | Bacillus |
| 16s rDNA sequence | GGGAAAGGCGGTGCTATACATGCAAGTCGAGCGGAGTTTTGAAAAGCTTGCTTTTCAAAACTTAGCGGCGGACGGGTGAG TAACACGTGGGCAACCTGCCCTTGAGACGGGGATAACTCCGGGAAACCGGAGCTAATACCGGATAACACATATCTTCGCA TGAGGATATGTTAGAAGGTGGCTTTTAGCTACCACTCAAGGATGGGCCCGCGGCGCATTAGCTAGTTGGTGAGGTAACGG CTCACCAAGGCGACGATGCGTAGCCGACCTGAGAGGGTGATCGGCCACACTGGGACTGAGACACGGCCCAGACTCCTACG GGAGGCAGCAGTAGGGAATCTTCCGCAATGGACGAAAGTCTGACGGAGCAACGCCGCGTGAGTGATGAAGGTTTTCGGAT CGTAAAGCTCTGTTGTTAGGGAAGAACAAGTATCTGTTGAATAAGCAGGTACCTTGACGGTACCTAACCAGAAAGCCACG GCTAACTACGTGCCAGCAGCCGCGGTAATACGTAGGTGGCAAGCGTTGTCCGGAATTATTGGGCGTAAAGCGCGCGCAGG CGGTTCCTTAAGTCTGATGTGAAAGCCCACGGCTCAACCGTGGAGGGTCATTGGAAACTGGGGAACTTGAGTGCAGAAGA GGAGAGCGGAATTCCACGTGTAGCGGTGAAATGCGTAGAGATGTGGAGGAACACCAGTGGCGAAGGCGGCTCTCTGGTCT GTAACTGACGCTGAGGCGCGAAAGCGTGGGGAGCGAACAGGATTAGATACCCTGGTAGTCCACGCCGTAAACGATGAGTG CTAAGTGTTAGAGGGTTTCCGCCCTTTAGTGCTGCAGCAAACGCATTAAGCACTCCGCCTGGGGGAGTACGGTCGCAGAC TGAAACTCAAAGGAATTGACGGGGACCCGCACAGCGGTGGAGCATGTGGTTTAATTCGAAGCAACGCGAAGAACCTTACC AGGTCTGACATCCTCTGCTACTTCTAAGAGATAGAAGGTTCCTTCGGGACGAGTGACAGGTGGTGCATGATTGTCGTCAGCTCGTGTCGTGAGATGTGGTAGTTCCCGCACGAGCGCACCCTTGATCTAGTGCAGCATTAGTGGCACCTCTAGGTGACTG CGTGACAACGGAGAGGTGGGATGACGTCAATCATTATGCTTAGACCTGGCTACACACGTGCCTAATTGAAATGTTTACAA AGGGCCGTGCTCTGCAAAA |
| Strain Morphology Photos | |
| Morphological Description | round;lychee white;edge neatly;steamed bun shaped;slippy;sticky;waxy;Rod;having spore;bias in budding spores |